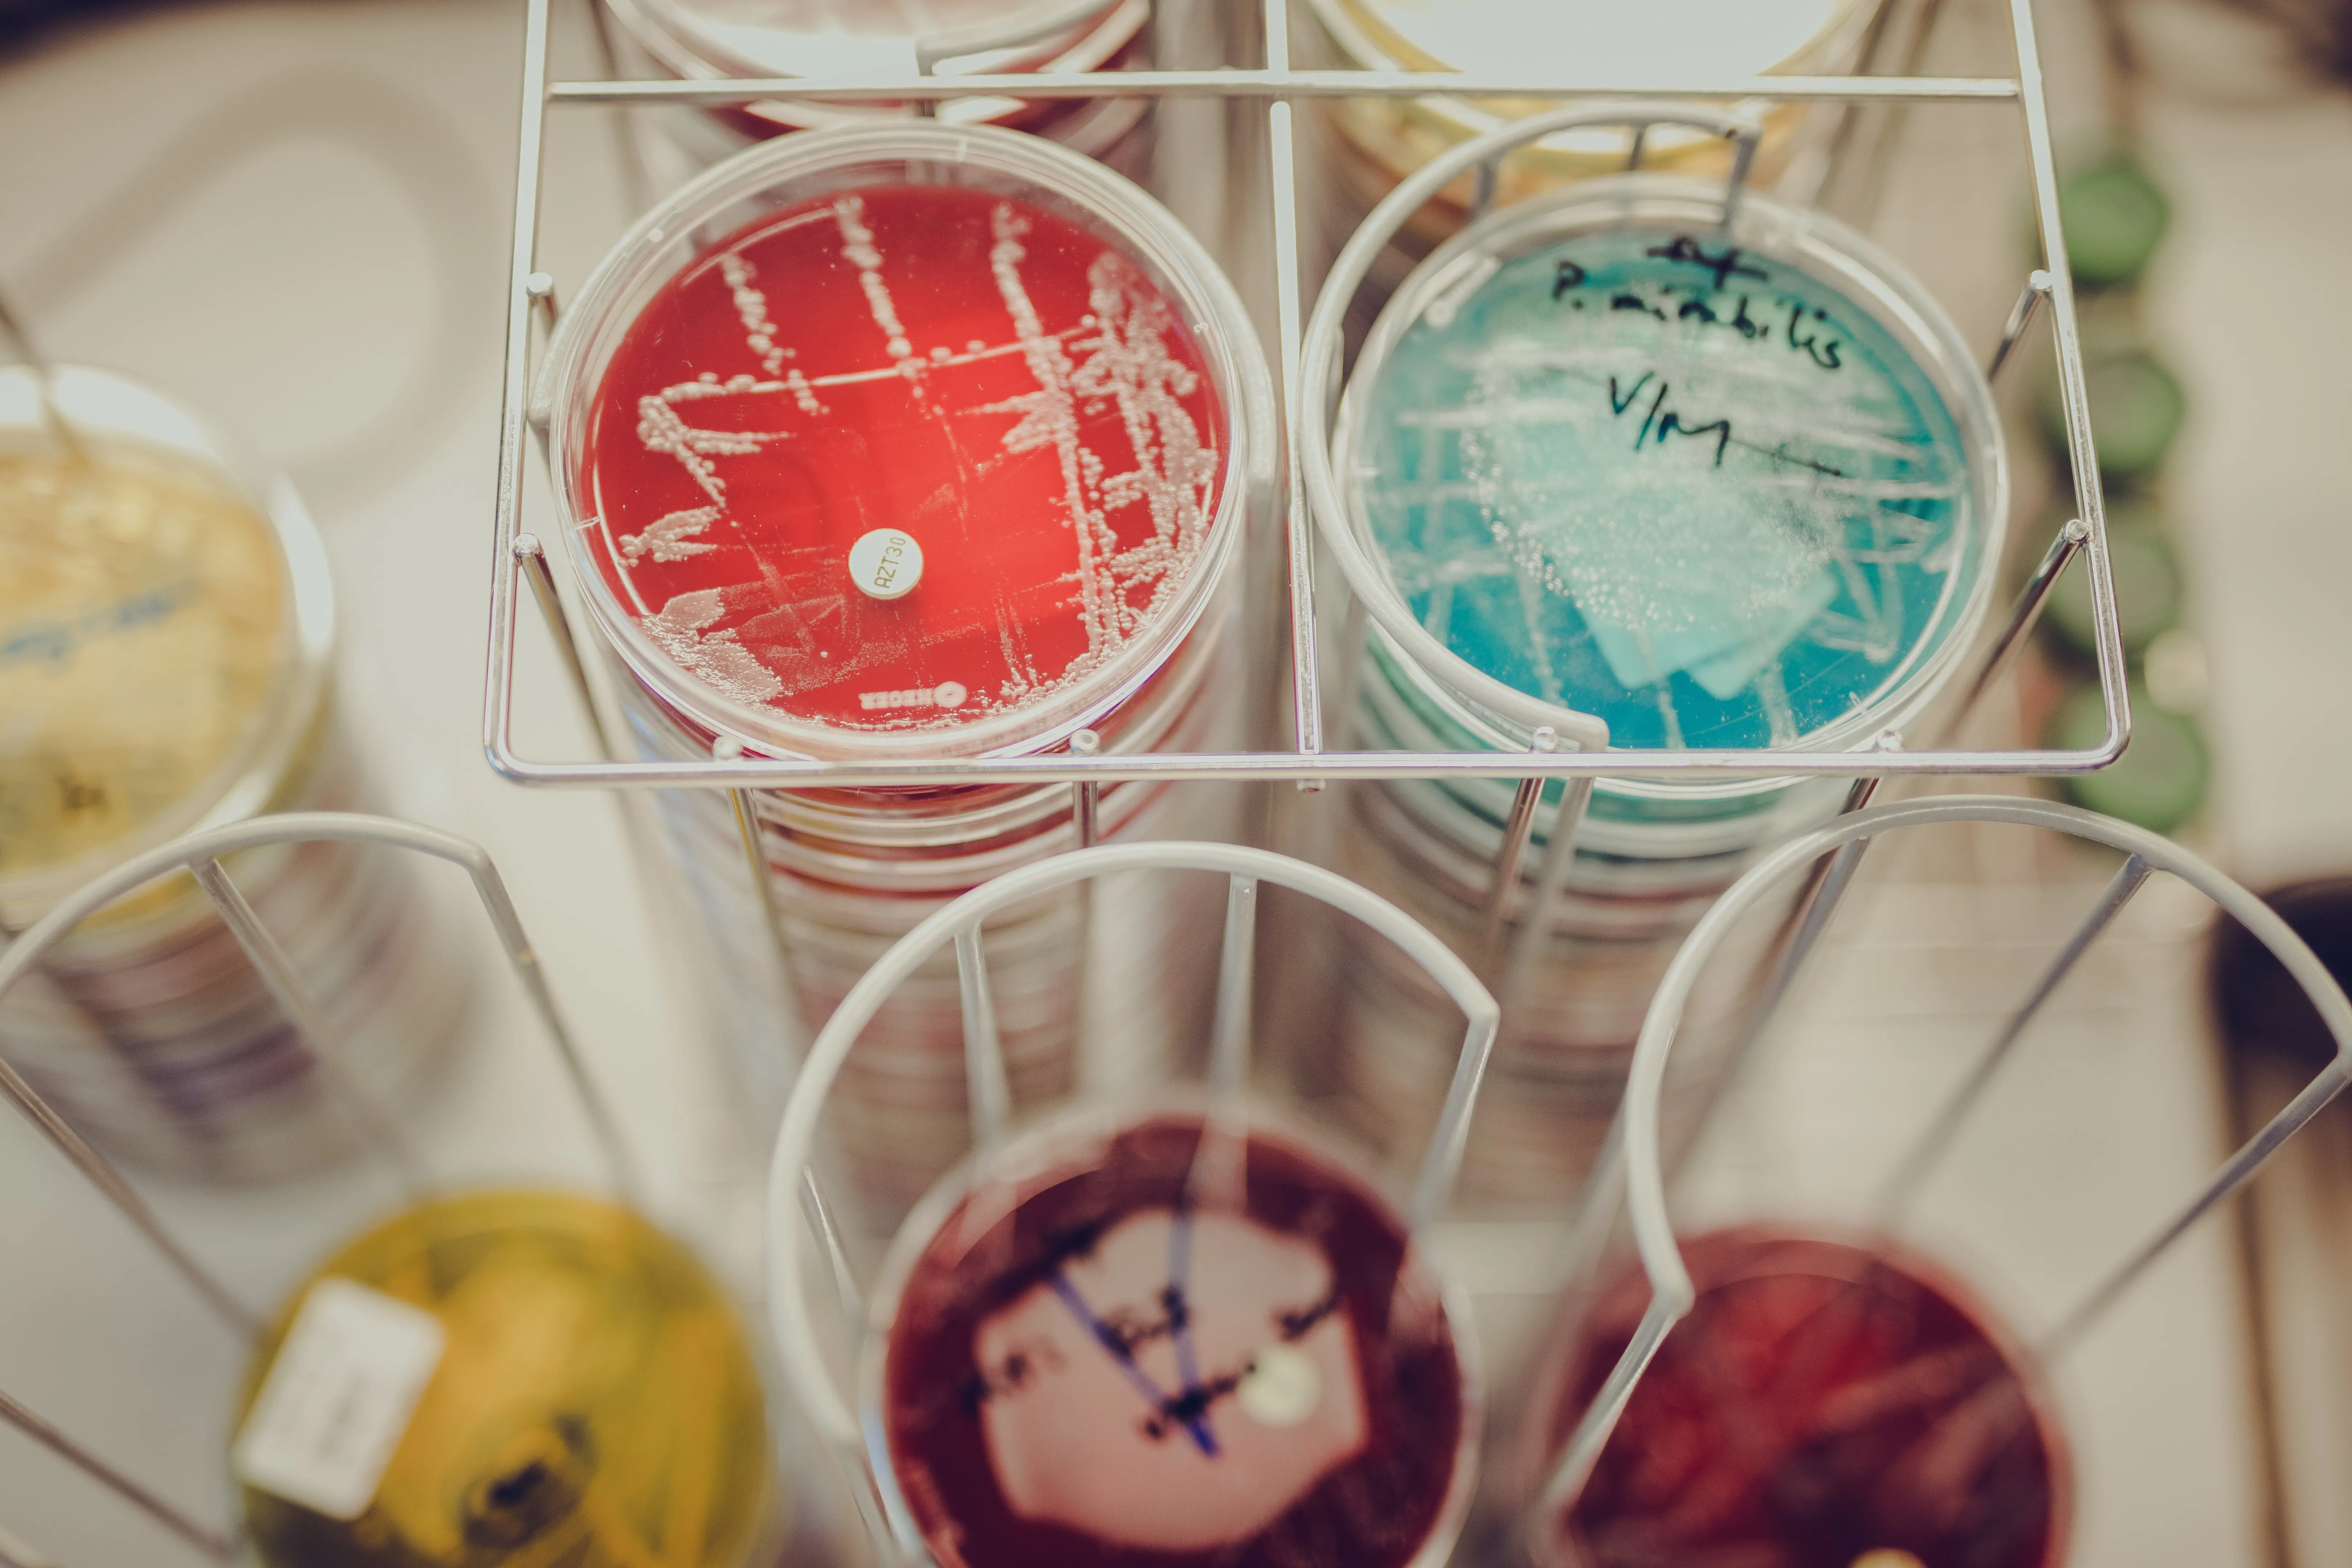

Alice (33) flyttet tilbake til hjembyen
- Sykehuset er stort nok til at man får vært med på mye, men lite nok til at man får varierte arbeidsoppgaver, sier bioingeniør Alice Lillegaard Pedersen.
Ida Kristin Dølmo, kommunikasjonsrådgiver
Publisert 19.11.2020
Sist oppdatert 30.03.2022

Bioingeniør Alice Lillegaard Pedersen (33) går gjennom de store, lyse lokalene ved Laboratoriemedisinsk avdeling. En lav summing av stemmer og maskinsus høres gjennom rommene.
- Her har vi topp moderne og nytt utstyr. På grunn av covid-19 ble mye bygget om for å utnytte plassen maksimalt. Her hadde vi ultrafrysere, men nå har vi fått inn nye PCR-maskiner, sier hun og fortsetter innover i korridoren.
Hun stopper opp ved Molekylærbiologisk enhet. På benken foran henne står stativer med prøverør med en klar, rosa væske. Disse skal nå analyseres for å bekrefte eller avkrefte positive prøvesvar på covid-19.
- Det har vært veldig spennende. Det er masse nytt å lære seg, og vi har fått mange nye instrumenter, forteller hun.
Flyttet hjem
33-åringen er født og oppvokst i Bodø. Yrkesveien bestemte hun seg for allerede i ungdomsårene.
- Jeg så et intervju på God Morgen Norge med en person som hadde leukemi. Der oppfordret de folk til å bli blodgivere, og man kunne også bli beinmarggiver. Jeg ble inspirert og undersøkte hva som skjer med blodet som kommer til blodbanken. Jeg fant ut at jobben gjøres av bioingeniører, og syntes det virket spennende å kunne hjelpe mennesker ved å bidra til rett diagnostisering, forteller hun.
Etter endt bachelorstudier i Tromsø, flyttet hun til Oslo, hvor hun har jobbet som bioingeniør både i offentlig og privat sektor. Da bodøværingen stiftet familie, tok hun med seg mann og barn og flyttet tilbake til hjembyen.
Ganske raskt fikk hun jobb ved Bakteriologisk enhet i Nordlandssykehuset. På grunn av koronapandemien, er hun for tiden lånt ut til Molekylærbiologisk enhet.
- Her har vi veldig fine lokaler. Det er flott og relativt nytt, med mange nye instrumenter. På Sentrallaboratoriet har de fått helt ny maskinpark. Det er et godt aldersspenn, slik at man vil finne kollegaer i samme livssituasjon. Det gjør det kjekt å jobbe her. God kjemi gjør at vi kan prate om ting man er interessert i, også utenom det faglige. Det er utrolig mange dyktige folk her, og mange med master- og doktorgrad. Vi oppfordres til å ta videreutdanning, og får lønn for utdanningen.
Artig med action
Laboratoriemedisinsk avdeling i Bodø har fire enheter: Blodbanken, Preanalytisk enhet, Sentrallaboratoriet og Mikrobiologisk enhet. I tillegg har helseforetaket laboratorium både i Vesterålen og i Lofoten. Sykehuset mottar prøver fra hele Nordland som de analyserer.
- Som bioingeniør ved Mikrobiologisk enhet, jobber vi med molekylærbiologiske metoder for å påvise RNA og DNA fra virus og bakterier, som herpes, klamydia, influensa og korona. Det som er fint med å jobbe her, er at man får innsikt i hele prøveflyten fra start til slutt. Vi mottar prøvene, registrer dem, analyserer dem og frigir svar. Det er fint å få være med på hele prøveflyten fra start til slutt, sier hun.
Pedersen skryter også av arbeidsmiljøet.
- Det er en utrolig trivelig gjeng å jobbe med, de står på, har godt humør og klager aldri.
Storslått natur
Småbarnsmoren setter pris på å komme tilbake til hjembyen, hvor naturen regjerer like utenfor bybildet.
- Jeg liker den storslåtte og fantastiske naturen, og at det er nært til alt. Flyplassen er nært byen, slik at det er lett å få besøk.
Som barnefamilie er de ofte i badeland, på flymuseet, i biblioteket eller i klatrehallen.
- I tillegg var vi heldige å kunne selge en liten leilighet i Oslo og kjøpe oss enebolig ikke langt fra sentrum, forteller hun.
Fin størrelse
Pedersen føler at hun har havnet på rett hylle i livet.
- Nordlandssykehuset er en lærerik plass å jobbe på. Det er fint med denne størrelsen på et sykehus: det er stort nok til å være med på mye, lite nok til at man ikke bare blir plassert i et hjørne og må konsentrere seg om én ting.
Hun skryter også av kompetansen hos kollegaer og samarbeidet med de ulike enhetene, faggruppene, legene, molekylærbiologene og lederne. Problemene har de løst etter hvert som de har dukket opp.
- Dette er en trygg plass å jobbe på, ettersom mange av analysene er akkreditert. Når svarene frigis, er bioingeniøren sikker på at hun har gitt et korrekt svar. Vi har strenge prosedyrer på kontroller, verifisering og validering. Vi har lært masse om hvordan vi best mulig kan gjøre ting. Det er mange veier til Rom.
